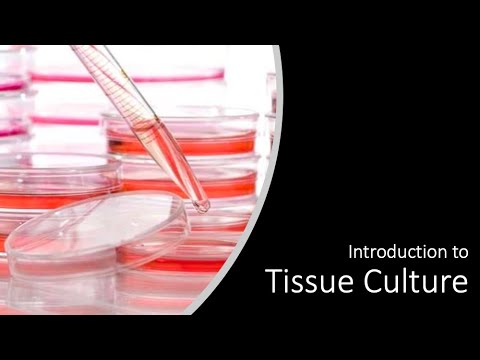

Created by Shivani Baisiwala, BS, MS, MD Candidate 2021 This video covers the basics of how to setup and interpret a proteomics screen. All research in this video is performed at the Ahmed Lab at Northwestern's Department of Neurosurgery, and is supported by the NIH and NINDS.